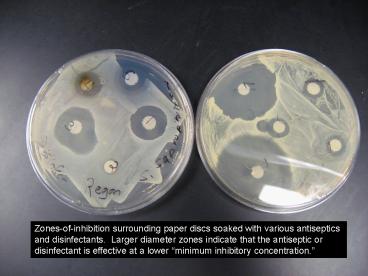

Zonesofinhibition surrounding paper discs soaked with various antiseptics and disinfectants' Larger
https://www.powershow.com/view/2561d7-YjAyY/Zonesofinhibition_surrounding_paper_discs_soaked_with_various_antiseptics_and_disinfectants_Larger_powerpoint_ppt_presentation
Icons create by Freepik from www.flaticon.com/